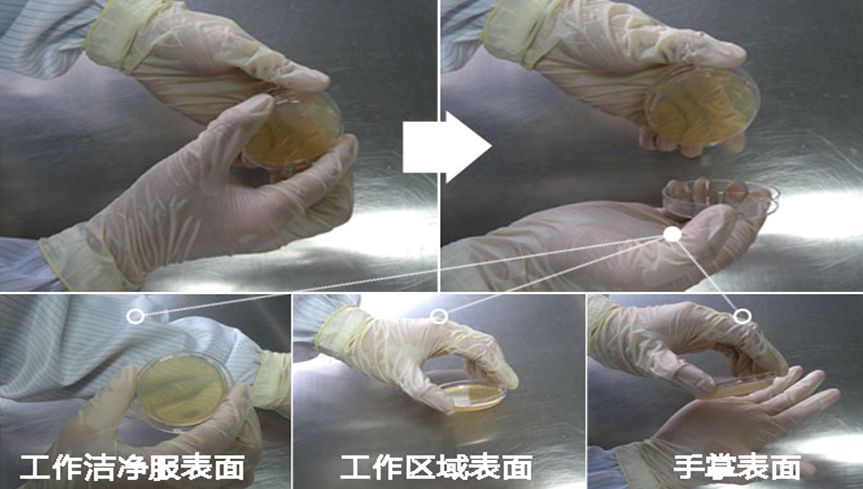

食品接触面风险与控制解决方案
发布时间:2018-07-10 浏览次数:8581 分享:
食品接触面的清洗可消除食物残渣和微生物生长的潜在风险
什么是食品接触面?
“食品接触面”顾名思义,是指直接或间接与食品接触的表面,包括器具及与食品接触之设备表面。美国GMP21CFRpart110中对“食品接触面”定义:指接触人类食品那些表面以及在正常加工过程中会将水滴溅在食品上或与食品接触的表面上的那些表面。
食品在生产加工过程中,食品接触面随处可见,根据食品可能污染来源途径,我们通常把食品接触面分成:直接与食品接触和间接与食品接触的表面。
直接接触的表面有:车间内的空气、加工设备、工器具、操作台案、转送带、储水池、内包装物料、加工人员的手或者手套和工作服等等;
间接接触的表面有:未经清洗消毒的冷库、车间的门把手、操作设备的按钮、车间内的开关、墙壁等。
由于接触面是一种介质,必然会有一部分迁移进入食品中,因此,食品接触面的卫生将直接影响生产过程的卫生。食品接触面的清洁卫生与食品接触面的结构、材料;清洗消毒方法和应用、清洁卫生的监测方法等息息相关,因此这些方面都是提高食品接触面卫生清洁有效性的重要因素。
一、食品接触面的结构
结构设计和安装应:无粗糙焊缝、破裂、凹陷,要求表面光边滑(包括缝、角和边在内);无不良关节连接、已腐蚀部位、暴露的螺丝和螺帽或其他可以藏匿水或污物的地方,真正做到表里如一。
目的:便于卫生操作,拆洗、维护、保养符合卫生标准要求,以及能及时充分的清洗清洁和消毒。
但是,我们常常会发现企业存在部分案板凹凸不平,焊缝粗糙;案台底部藏污纳垢;传送带底部霉菌滋生等,这些结构方面的问题常常造成食品接触面的卫生清洁不到位,由此造成在进行食品接触面检测时,致病菌被检出屡见不鲜。
如:某水产加工企业的拌糊机由于设计上存在弯管太多,部分区域成了卫生死角而无法清理消毒彻底,在对食品接触面检测中发现存在单核细胞增生李斯特氏菌,导致成品在检测中同样检出单核细胞增生李斯特氏菌,造成企业损失巨大。因此食品接触面的设计、安装与食品接触面的清洁卫生息息相关。

二、食品接触面的材料
食品接触面的材料应是符合食品安全卫生要求的“安全”的材料。“安全”的材料是指:无毒(无化学物渗出)、不吸水(不积水和/或干燥)、抗腐蚀、不与清洗剂和消毒剂产生化学反应。
与食品产品接触材料的要求有:

三、食品接触面清洗消毒方法和应用
清洗消毒方法和应用清洗和消毒食品接触面是控制病原微生物的基础。
1、清洗消毒的方法
1)物理方法。臭氧消毒、电子灭菌消毒、紫外线消毒等。肉类加工厂应首选82℃热水清洗消毒。臭氧、紫外线灯消毒大多针对生产空间或工作服等的消毒。
2)化学方法。一般使用含氯消毒剂,如次氯酸钠100~150mg/kg。
2、清洗消毒程序
使用化学清洗剂时一般分5~6个步骤:

3、食品接触面清洁卫生的监测

1)监测的对象: 包括食品接触面的状况;食品接触面的清洗和消毒;使用的消毒剂类型和浓度;可能接触食品的手套和外衣是否清洗卫生,且状态良好。
2)监测方法 包括感官检查、化学检测和验证检查。
监测方法 | 目的 | 应用 | 说明 |
感官检查 | 表面状况良好,表面已清洗和消毒,手套和外衣清洗且保养良好。 | 感官检查是直接有效的方法,使用强光或其他无黑影的光源检查暗处。 | 美国 FDA在来华检查工厂时曾经带着手电检查过工厂开工前的食品接触面的卫生状况。 |
化学检测 | 确认消毒剂的浓度是否符合规定要求(试纸条或试剂盒,化学滴定) | 试纸条是测定消毒剂浓度最常用的方法,具有快速、低耗费、不需要实验室设备和化学试剂,可以现场操作,不需要太多的培训等优点。 | 不是在加工厂使用的所有消毒剂都有合适的检测试纸,通常只是对消毒剂浓度或者浓度的范围进行估计。 |
验证检查 | 是指表面微生物检测,检测方法主要包括接触平板、棉拭涂抹和发光法,可以定期评价工厂食品接触面清洁消毒的有效性。 | 接触平板只要接触一下要检查的表面然后覆盖上保护盖、膜或者套。经放置培养几天后,平板上菌落的数目是清洁和消毒效果的良好指示。 | 这些方法都是微生物检测方法,检测过程比较缓慢,不能在开工前显示问题并及时纠正。 |
用无菌的面拭子擦拭某一区域,转入液体培养基,以后接种培养。 |
|
|
|
发光法是基于萤火虫光的酶反应原理。在检测过程中,光的亮度与表面的细菌和食品残渣的数量成正比。 | 克服了微生物检测方法耗时长的弱点,但在某些情况下,因为有食品残渣导致仪器显示的读值较高,而表面微生物的数量却很低, |
|
|
3)监测频率
感官检查频率:一般在每天加工前、加工过程中以及生产结束后进行。洗手消毒主要在员工进入车间时、从卫生间出来后和加工过程中检查。
实验室检测频率:按实验室制定的抽样计划,一般每周1~2次。虽然微生物检测周期长使食品接触面的监控滞后,但在微生物检测数据汇总统计的基础上,探索一套针对不同结构材料食品接触面而采用不同清洁消毒试剂的浓度和方法的计划或方案是切实可行的。通过微生物检测加以验证,根据验证结果动态调整计划或方案,可以达到既节约企业成本又提高食品接触面清洁卫生有效性的目的,为企业生产出安全卫生健康的产品保驾护航。
环凯为食品接触面清洁卫生的微生物检测提供的整套解决方案
所需的仪器试剂 性能特点 用途说明 规格 ATP荧光定量 检测微生物总量可达到到1.0 CFU/ml,10秒出结果。 快速检测接触面微生物数量。 1台 PC006 Clean-ChekTM表面洁净度检测棒 检测棒拭子端含有与蛋白反应的试剂,主要检测食品样品中蛋白的残留;根据检测棒颜色变化直接判断结果,即时出结果,无需实验室设备、无需培养。 采用化学反应原理监测食品接触面清洁的程度。 50条检测棒(100次测试) 060061湿式餐具大肠菌群检验纸片 开袋即用,无需润湿。定量采样,每片纸片采样面积25cm2.根据纸片菌落颜色判读结果。 用于表面大肠菌群快速检测。 10 包/盒(10 片/包) PC080 Path-Chek Hygene李斯特氏菌检测肉汤 测试后根据Path-Chek Hygiene单核细胞增生李斯特氏菌检测肉汤变色判读结果,变黑色为阳性,结果记为检出;变黄色或麦秆色为阴性,结果记为未检出。 用于表面单核细胞增生李斯特氏菌快速检测。 PC020 Path-Chek Hygene 沙门氏菌检测肉汤 测试后根据Path-Chek Hygiene沙门氏菌检测肉汤变色判读结果,变黑色为阳性,结果记为检出;变黄色或紫色为阴性,结果记为未检出。 用于表面沙门氏菌快速检测。 028074P1胰酪大豆胨琼脂培养基(大豆酪蛋白琼脂培养基) 脱水颗粒型,环保无粉尘;遇水即化,不粘壁。 用于生产环境中沉降菌、浮游菌、接触面微生物检测。 250g/瓶 021098P1沙氏葡萄糖琼脂培养基 CP0201J TSA接触皿(三层无菌包装) 即用型成品,使用时开盖直接贴于需检测的规则表面即可完成采样。采样后按标准要求进行培养再读结果。 用于接触面微生物检测。 55mm×10个,25cm2/皿采样面积 CP0301J SDA接触皿(三层无菌包装) CP0101J NA接触皿(三层无菌包装) CP0202J TSA+β内酰胺酶接触皿(三层无菌包装) CP0204J TSAWLP 接触皿(TSA+卵磷脂+吐温80) (三层无菌包装)
工作台(机械器具)与工人手表面接触皿采样法

中间会有部分培养基突出过底皿最高边缘,采样过程只需轻压培养皿,使突出部分培养基与取样点接触一定时间,然后盖上盖子在培养箱中培养计数即可。
所需试剂:
PC080 Path-Chek Hygene李斯特氏菌检测肉汤
PC020 Path-Chek Hygene沙门氏菌检测肉汤
使用操作示意图:

1、 取出拭子

2、涂抹采样

3、 折断拭子培养

4、结果判读






